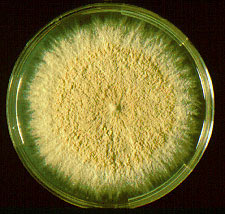

Allergologie Phlebologie
Dermatologische Lasertherapie
Ambulante Operationen
Ästhetische Dermatologie
Medizinische Kosmetik
Dermatologie Frechen
Gemeinschaftspraxis
Dr. med. Jan Hundgeburth
Dr. med. Felix B. Müller
Gesundheitscentrum Frechen
Alfred-Nobel-Straße 50-52
50226 Frechen
Tel. 0 2234 - 999 2234
Fax 0 2234 - 999 2233
Mykologie
|
Mykosen sind weit verbreitete, durch Pilze hervorgerufene, Erkrankungen der Haut und Schleimhäute. Ebenso können Haare und Nägel betroffen sein. Zur Abklärung von Pilzerkrankungen der Haut werden Hautproben im eigenen Labor mikroskopisch und kulturell untersucht. Hierdurch können die krankheitsauslösenden Pilze genau charakterisiert und fachgerecht gemäß aktueller therapeutischer Leitlinien behandelt werden. Neben den klassischen mikroskopischen und kulturellen Verfahren zum Nachweis von Pilzmaterial bieten wir auch ein hochmodernes, PCR-basiertes Diagnostikverfahren an. Mithilfe der Myco-PCR lassen sich innerhalb kurzer Zeit zahlreiche Pilzspezies nachweisen, die Infektionen von Haut, Haaren und Nägeln verursachen können. Im Vergleich zur kulturellen Untersuchung ist die Myco-PCR deutlich empfindlicher und liefert insbesondere bei bereits medikamentös vorbehandelten Pilzinfektionen zuverlässige und aussagekräftige Ergebnisse. |
|

